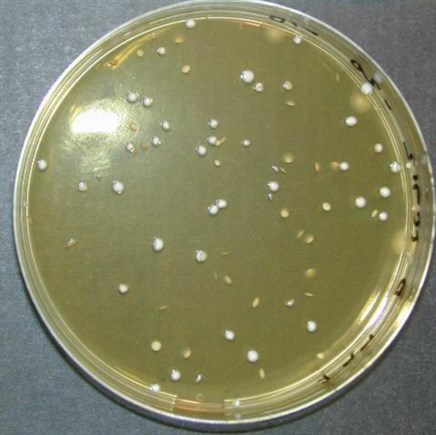

樂多珠珠/力多珠珠®是壹種特有的已被證明能促進人類健康的益生菌。
樂多珠珠/力多珠珠®益生菌株的學名是鼠李糖乳桿菌GG (ATCC 53103),縮寫為 “乳酸桿菌GG”。樂多珠珠/力多珠珠®中採用的菌株是由兩位波士頓科學家,Prof. Sherwood L. Gorbach and Dr. Barry Goldin,於壹九八五年從壹位健康實驗對象的腸道中所分離出的壹種特定的益生菌株. “GG” 這名稱就是隨這兩名發現者而命名的。
截止到2020年,珠珠益生菌已擁有超過1100份科研文章及超过300項臨床實驗報告, 使這特別的益生菌株(珠珠益生菌)成為益生菌效益的 “黃金標準”。